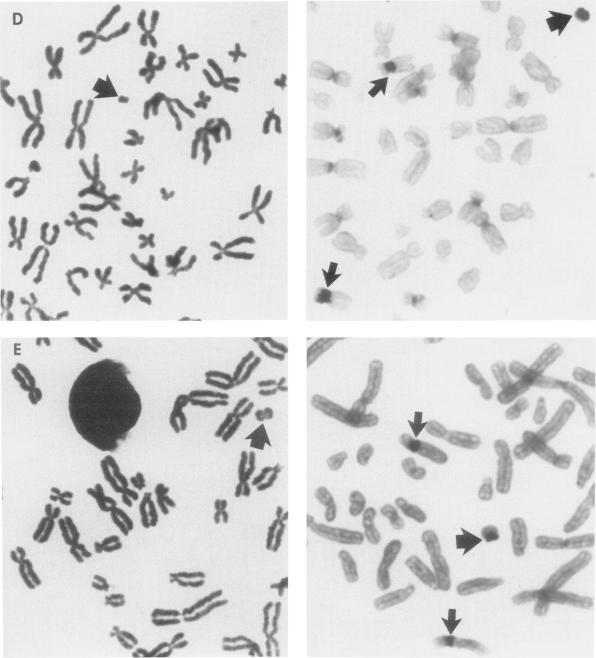
https://cdn.ncbi.nlm.nih.gov/pmc/blobs/aba3/1682952/03b4df6a1b8f/ajhg00088-0140-a.jpg

人类小环状标记染色体的染色体起源:分子遗传学特征分析
Chromosomal origin of small ring marker chromosomes in man: characterization by molecular genetics.
作者信息
Callen D F, Eyre H J, Ringenbergs M L, Freemantle C J, Woodroffe P, Haan E A
机构信息
Department of Cytogenetics and Molecular Genetics, Adelaide Children's Hospital, Australia.
出版信息
Am J Hum Genet. 1991 Apr;48(4):769-82.
Ten cases of small ring chromosomes which did not stain with distamycinA/DAPI and did not possess satellite regions associated with nucleolus-organizing regions are described. In situ hybridization with a battery of biotinylated pericentric repeat probes specific either for individual chromosomes or for groups of chromosomes allowed the identification of the chromosomal origin of these marker chromosomes. There was one example of a marker derived from each of chromosomes 1, 3, 6, 14, 16, 18, 20, 13 or 21, and the X, and there were two examples of markers derived from chromosome 12. One case possessed two markers, one derived from chromosome 6, and one derived from the X. The mechanism of generation of ring marker chromosomes is discussed. Five of seven cases who could be phenotypically assessed were abnormal. Three of these--the first with a ring chromosome derived from chromosome 1; the second with two markers, one derived from chromosome 6 and the other from the X chromosome; and the third with a ring chromosome derived from chromosome 20--each possessed distinctive facies. Additional cases with identified rings may allow the delineation of new chromosomal syndromes.
本文描述了10例小环状染色体,这些染色体不被放线菌素A/ DAPI染色,且不具有与核仁组织区相关的随体区域。使用一系列针对单个染色体或染色体组的生物素化着丝粒重复探针进行原位杂交,从而确定了这些标记染色体的染色体来源。其中,分别有1号、3号、6号、14号、16号、18号、20号、13号或21号染色体以及X染色体衍生的标记染色体各1例,还有2例标记染色体源自12号染色体。有1例患者拥有两个标记染色体,一个源自6号染色体,另一个源自X染色体。本文还讨论了环状标记染色体的产生机制。在7例可进行表型评估的患者中,有5例存在异常。其中3例——第一例具有源自1号染色体的环状染色体;第二例有两个标记染色体,一个源自6号染色体,另一个源自X染色体;第三例具有源自20号染色体的环状染色体——各自具有独特的面容。更多已确定环状染色体的病例可能有助于明确新的染色体综合征。